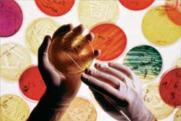

Prodotti
La ketamina è una molecola di origine sintetica dalle proprietà anestetiche ed analgesiche ed è ampiamente utilizzata in ambito veterinario, molto meno come anestetico nell’uomo.
Nel mercato illecito si trova sotto forma di liquido, capsule e polvere cristallina. La ketamina è stata rilevata anche in compresse vendute come ecstasy o come adulterante di altre droghe quali cocaina, amfetamine, eroina.
Nell’uso non medico, la ketamina in polvere viene principalmente assunta per via inalatoria, o iniettata per via intramuscolare dopo averla portata in soluzione. Viene riportata anche l’assunzione per via orale, rettale o anche attraverso il fumo, in via endovenosa o intramuscolare.